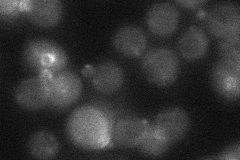
YLR319C

View description
Actin- and formin-interacting protein, involved in actin cable nucleation and polarized cell growth; isolated as bipolar budding mutant; potential Cdc28p substrate
Localization:
Intensity:
Fold change:
Significance:
-
C’ GFP library in SD

below threshold16.43 -
N' NOP1pr-GFP in SD

punctate,bud neck61.7857 -
N' TEF2pr-mCherry in SD

punctate,bud neck84.7159 -
N' NATIVEpr-GFP in SD
bud neck26.4427 -
N' TEF2pr-VC and Cyto-VN in SD

punctate32.8575 -
C’ GFP library in SD+DTT

cytosol17.151.04No -
C’ GFP library in SD+H2O2

cytosol16.691.01No -
C’ GFP library in Starvation Media

cytosol18.61.13No -
C’ GFP library on the background of Pup2-DaMP

below threshold -
C’ GFP library on the background of CCT mutant

below threshold16.43080.999512No
